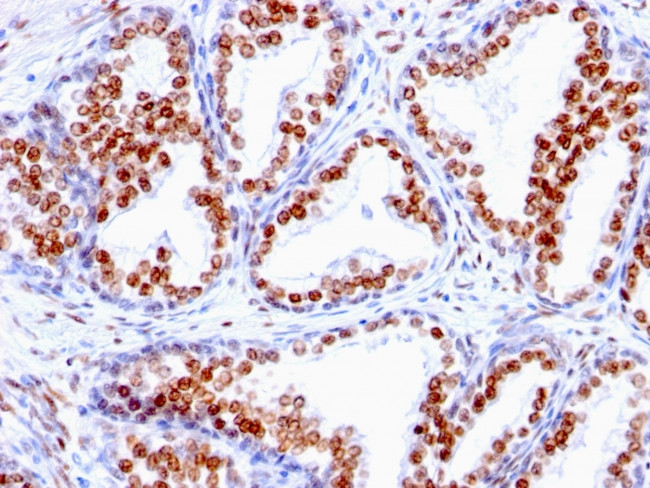
Androgen Receptor (Marker of Androgen Dependence) Antibody in Immunohistochemistry (Paraffin) (IHC (P))

Search
NeoBiotechnologies
Androgen Receptor (Marker of Androgen Dependence) Monoclonal Antibody (SPM335)
{{$productOrderCtrl.translations['antibody.pdp.commerceCard.promotion.promotions']}}
{{$productOrderCtrl.translations['antibody.pdp.commerceCard.promotion.viewpromo']}}
{{$productOrderCtrl.translations['antibody.pdp.commerceCard.promotion.promocode']}}: {{promo.promoCode}} {{promo.promoTitle}} {{promo.promoDescription}}. {{$productOrderCtrl.translations['antibody.pdp.commerceCard.promotion.learnmore']}}
产品信息
367-MSM1X-P0
种属反应
宿主/亚型
分类
类型
克隆号
抗原
偶联物
形式
浓度
纯化类型
保存液
内含物
保存条件
运输条件
产品详细信息
Does not react with Mouse
靶标信息
The androgen receptor (AR) is a member of the steroid-hormone receptor superfamily of nuclear receptors. The receptor is more than 90 kDa and has three major functional domains: the N-terminal domain, DNA-binding domain, and the androgen-binding domain. The androgen receptor is a ligand-activated transcription factor that binds active testosterone (T) and dihydrotestosterone (DHT). Upon binding the hormone ligand, the receptor dissociates from accessory proteins, translocates into the nucleus, dimerizes, and then stimulates transcription of androgen responsive genes. The AR signaling pathway plays a key role in development and function of male reproductive organs, including the prostate and epididymis. AR also plays a role in nonreproductive organs, such as muscle, hair follicles, and brain. Androgen Receptor is a phosphoprotein, and also regulates mitogen-activated protein kinase (MAP kinase). The inhibition of the MEK1/2 pathway correlates directly with a change in phosphorylation state of the androgen receptor. Abnormalities in the AR signaling pathway have been linked to a number of diseases, including prostate cancer, Kennedy's disease, and male infertility. Mutations in this gene are associated with complete androgen insensitivity (CAIS).
仅用于科研。不用于诊断过程。未经明确授权不得转售。
篇参考文献 (0)
生物信息学
蛋白别名: androgen nuclear receptor variant 2; Androgen receptor; androgen receptor splice variant 4b; AR-A; Dihydrotestosterone receptor; Nuclear receptor subfamily 3 group C member 4; RP11-383C12.1; Variant AR45
基因别名: AIS; AR; AR8; DHTR; HUMARA; HYSP1; KD; NR3C4; SBMA; SMAX1; TFM
UniProt ID: (Human) P10275
Entrez Gene ID: (Human) 367